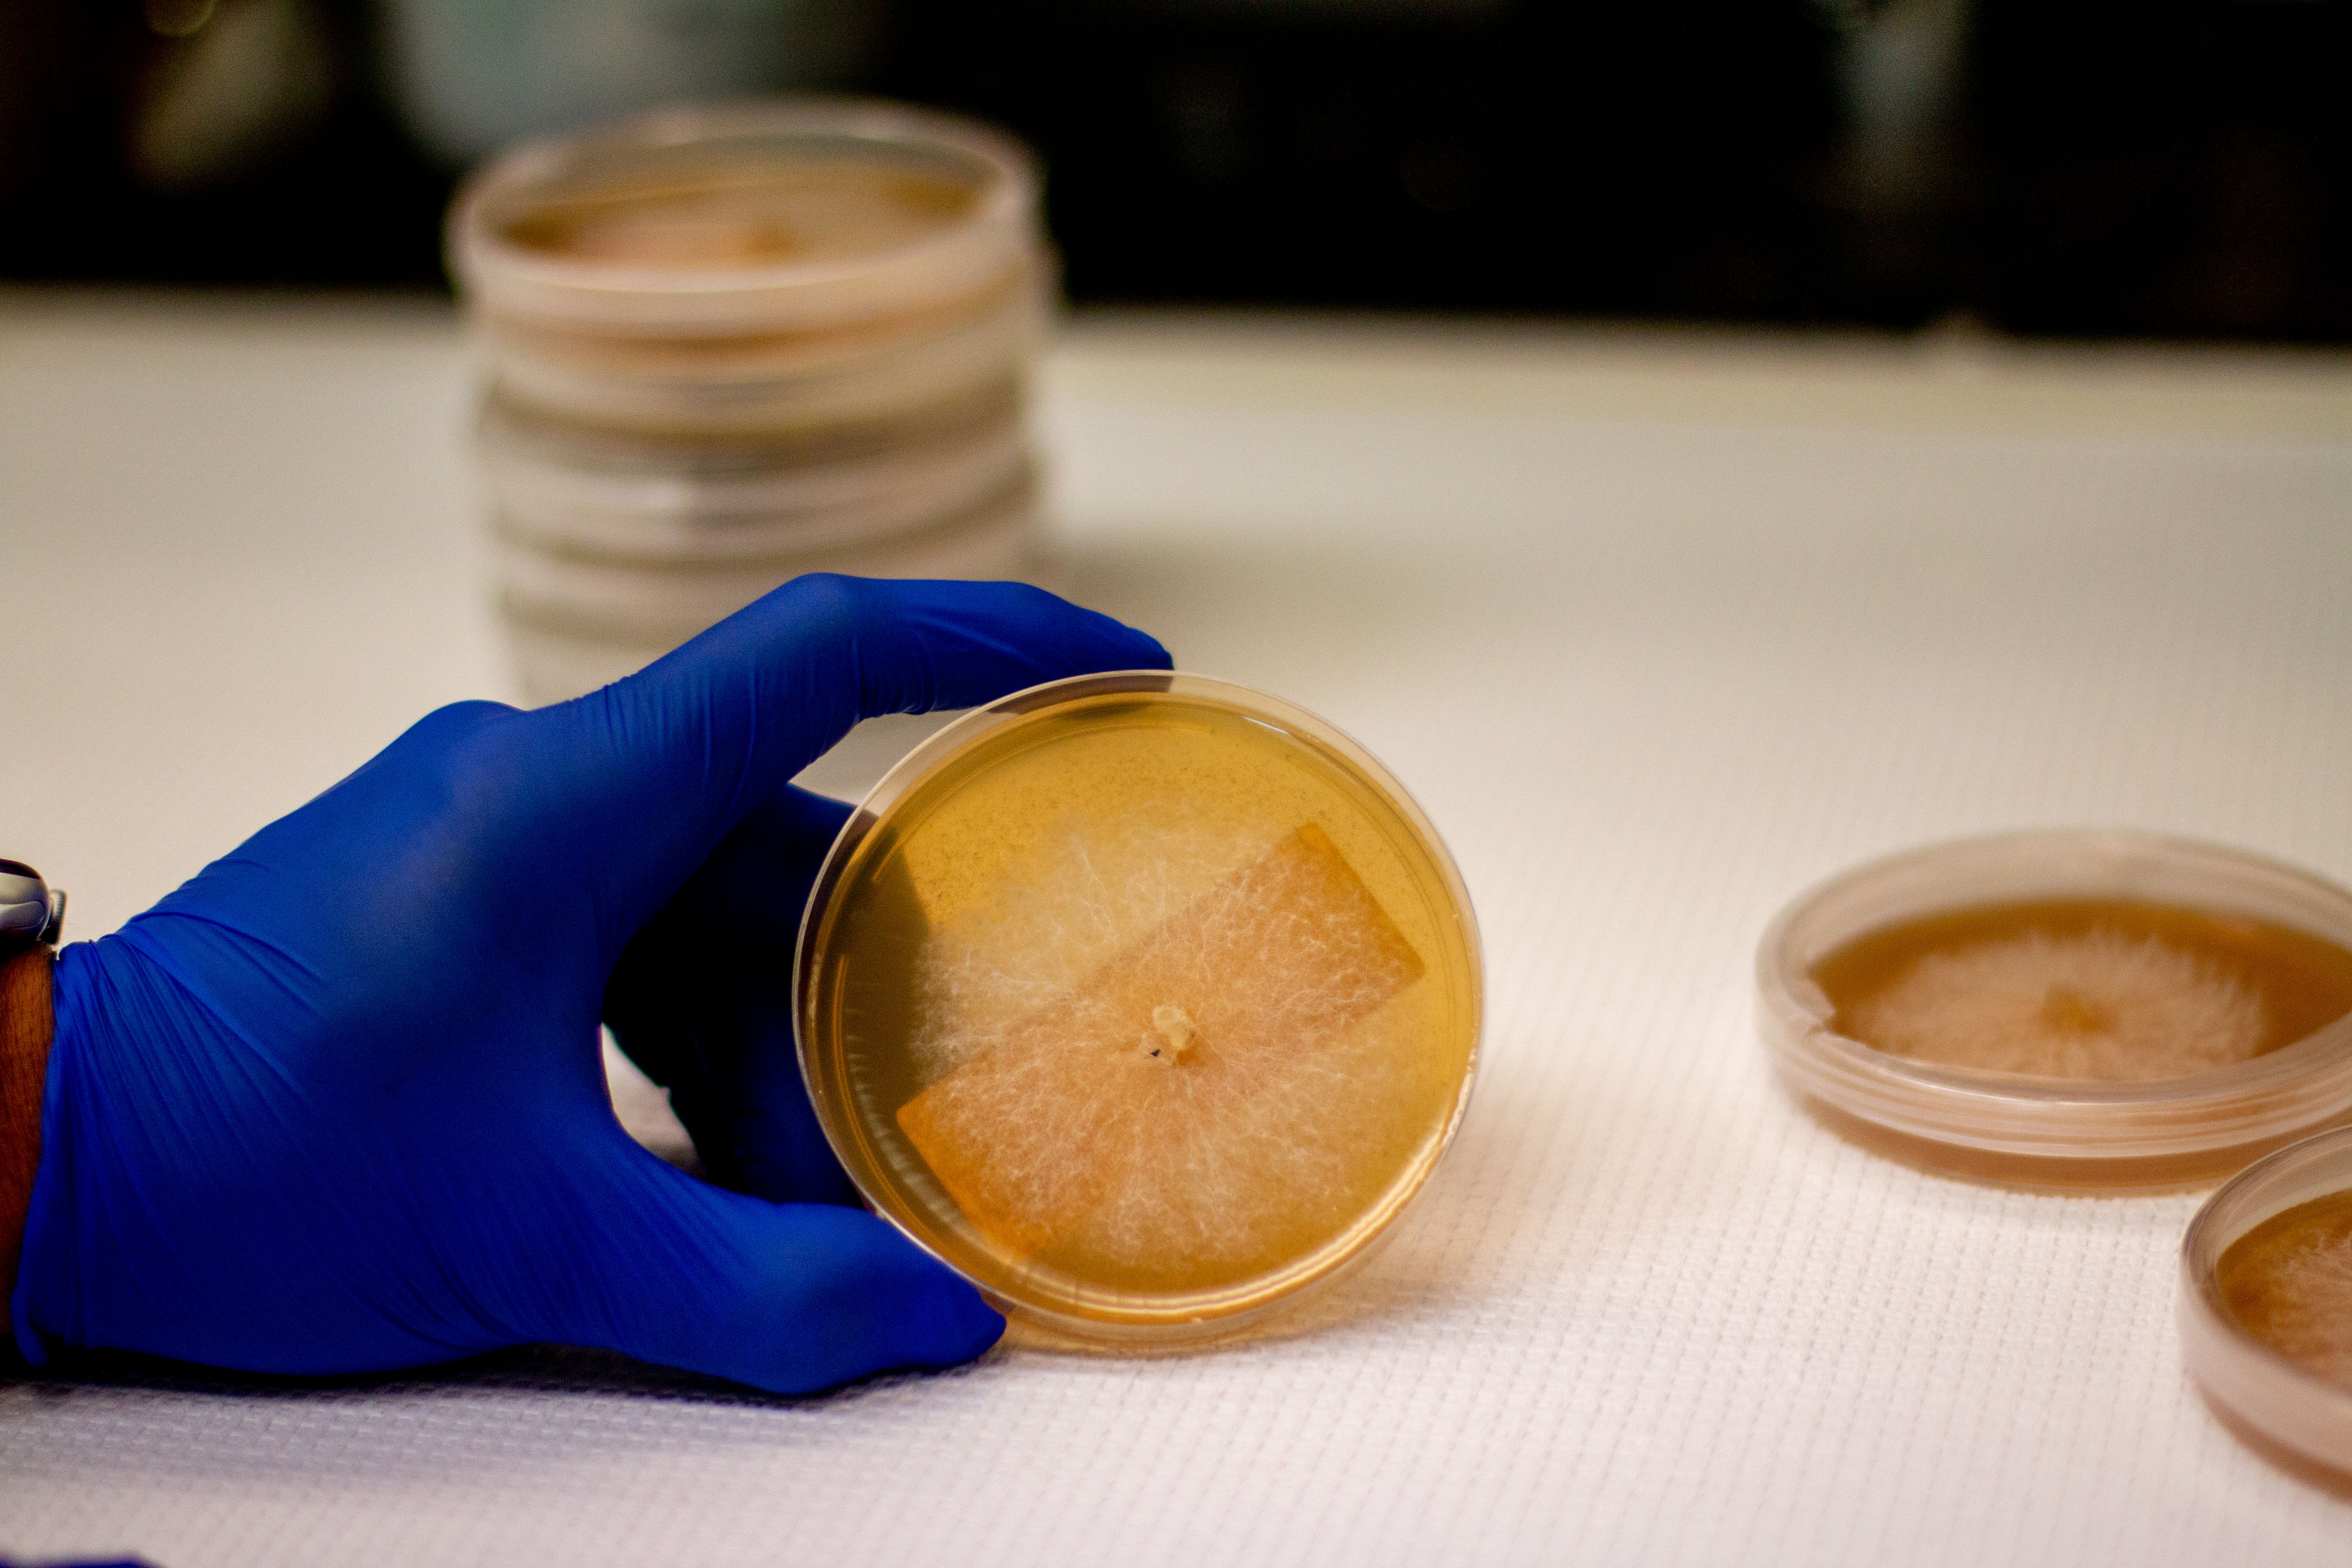
Amycel-Production-12

Stability
We've been doing this since 1979. The industry has changed. Our commitment hasn't.
Career Opportunities
We’re a global team. Scientists, researchers, operations, and support reps across four facilities on two continents, serving growers in 37 countries. The work is real. The culture is close-knit. And we’ve been at it long enough to know that the people are what make the difference.


We've been doing this since 1979. The industry has changed. Our commitment hasn't.

37 countries. 5 continents. There's real scale to what we do.
Our research and products shape how commercial mushrooms are grown worldwide.

We're a family and community-oriented business, and it's how we operate.

